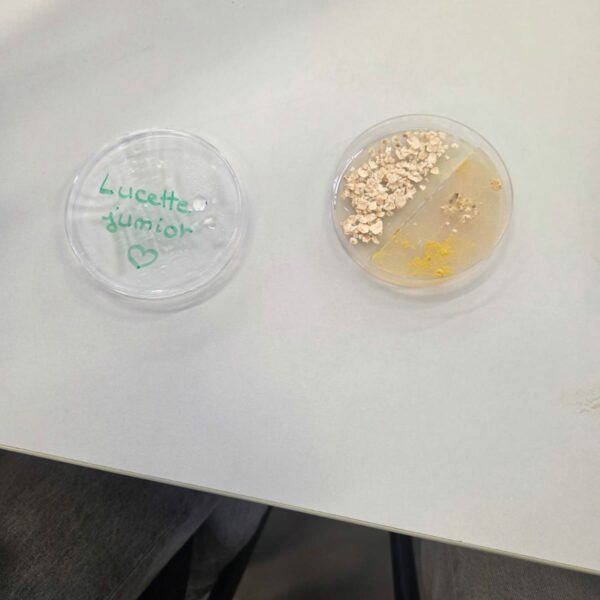
PHOTO-2025-11-17-15-29-09_2
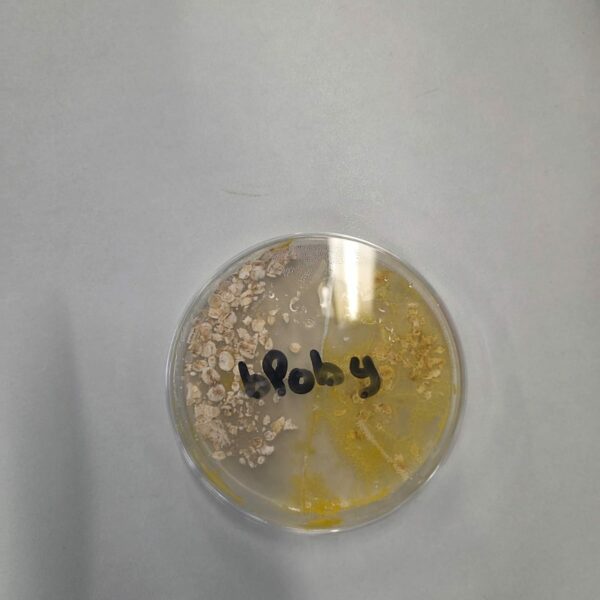
PHOTO-2025-11-17-15-29-09
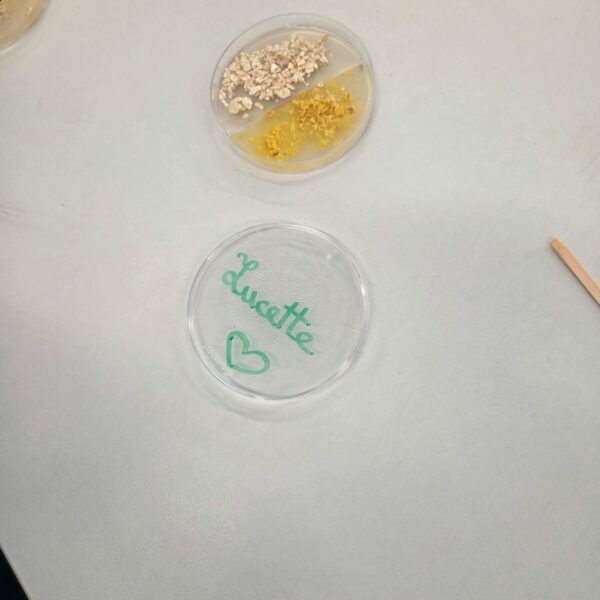
PHOTO-2025-11-17-15-29-09_1

01 Déc Atelier scientifique en 3ème Eurêka
Le 17 novembre, la 3ème Eurêka, la classe à projet qui étudie les sciences, avec Mesdames Taraud et Mardelé, leurs professeures de SVT (sciences de la Vie et de la Terre), sont allés au Dôme de Caen pour découvrir ce qu’est un protocole scientifique et comment le suivre, autour d’un objet d’étude bien curieux : le Blob ! Le blob est un être vivant sans yeux, ni bouche, ni pattes. Il peut se déplacer jusqu’à 1 centimètre toutes les heures. Il n’a pas non plus de cerveau mais il est intelligent, et il apprend vite. Cette curiosité quasi-immortelle ne craint que la lumière et la sécheresse. Il est aussi capable de cicatriser alors qu’il a été découpé en morceaux ! Les 3èmes ont trouvé cet atelier très intéressant et enrichissant, et ont pu ramener un spécimen chez eux. Les autres ont été rapportés au collège pour faire d’autres expériences.